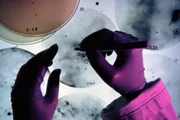

Registrierung zur E-Mail-Benachrichtigung
Anmeldung zur kostenlosen Serienstart-Benachrichtigung für
- E-Mail-Adresse
- Für eine vollständige und rechtzeitige Benachrichtigung übernehmen wir keine Garantie.
- Fragen & Antworten
Cold Case Files - Wahre Fälle der US-Ermittler
(Cold Case Files) USA, 1999–

- kostenlose E-Mail-Benachrichtigung bei TV-Termin oder DVD-VÖ
- 04.03.: Neue komplette Folge: Cold Case Files - Die Rifkin-Morde (Crime + Investigation)
- 03.03.: Neue komplette Folge: Cold Case Files - Die Rifkin-Morde (Sky GO)
- 03.03.: Neue komplette Folge: Cold Case Files - Der Grim Sleeper (WOW Channel)
- 03.03.: Neue komplette Folge: Cold Case Files - Der Grim Sleeper (WOW Channel)
- 03.03.: Neue komplette Folge: Cold Case Files - Die Rifkin-Morde (Sky GO)
- 28.02.: Neue komplette Folge: Die Suche einer Tochter (Joyn)
- 21.02.: Neue komplette Folge: Verscharrt im Wald (Joyn)
- 17.02.: Neue komplette Folge: Das heilige Versprechen (Joyn)
- 12.02.: Neue komplette Folge: Cold Case Files (Crime + Investigation)
- 12.02.: Neue komplette Folge: Cold Case Files (Apple TV Store)
- 10.02.: Neue komplette Folge: Cold Case Files - Der Grim Sleeper (WOW Channel)
- 10.02.: Neue komplette Folge: Cold Case Files - Die Rifkin-Morde (Sky GO)
- 10.02.: Neue komplette Folge: Cold Case Files - Der Grim Sleeper (WOW)
- 09.02.: Neue komplette Folge: Cold Case Files (Crime + Investigation)
- 08.02.: Neue komplette Folge: Festival-Queen (Joyn)
- 06.02.: Neue komplette Folge: Grauen zu Halloween (Prime Video Shop)
- 06.02.: Neue komplette Folge: Wehrlose Opfer (Prime Video Shop)
- 06.02.: Neue komplette Folge: Wehrlose Opfer (Apple TV Store)
- 06.02.: Neue komplette Folge: Grauen zu Halloween (Apple TV Store)
- 06.02.: Neue komplette Folge: Die 17 Morde (Crime + Investigation)
- 06.02.: Neue komplette Folge: Das letzte Puzzleteil (Crime + Investigation)
- 05.02.: Neue komplette Folge: Die 17 Morde (Sky GO)
- 05.02.: Neue komplette Folge: Das letzte Puzzleteil (Sky GO)
- 05.02.: Neue komplette Folge: Cold Case Files - Die Rifkin-Morde (Sky GO)
- 05.02.: Neue komplette Folge: Teil 2 (WOW Channel)
- 05.02.: Neue komplette Folge: Teil 1 (WOW Channel)
- 05.02.: Neue komplette Folge: Teil 2 (WOW)
- 05.02.: Neue komplette Folge: Teil 1 (WOW)
- 04.02.: Neue komplette Folge: Cold Case Files - Die Rifkin-Morde (WOW)
- 31.01.: Neue komplette Folge: Tödliches Inferno (Joyn)
- Platz 1231
149 Fans - Serienwertung5 121354.58von 12 Stimmeneigene: –
Bildergalerie zu "Cold Case Files - Wahre Fälle der US-Ermittler"
Tödliche AbkürzungBild: © 2016 A+E Networks, LLC. (C)A&E Phoctocredit Mandatory, Editorial Use Only, NO archive, NO Resale
Die Stimme aus dem SeeThe forestBild: © box / © Crime + Investigation / A+E Networks
Tödliche AbkürzungBild: © 2016 A+E Networks, LLC. (C)A&E Phoctocredit Mandatory, Editorial Use Only, NO archive, NO Resale
Vermisst in AltoonaSunsetBild: © box / © Crime + Investigation / A+E Networks
Vermisst in AltoonaCold Case Files EP Vermisst in AltoonaBild: © box / © Crime + Investigation / A+E Networks
Folge 11Das Appartement von Susan Eigen, in dem sie und ihr Sohn ermordet wurden ...Bild: © kabel eins Eigenproduktionsbild frei
GroßfahndungBild: © 2016 A+E Networks, LLC. (C)A&E Phoctocredit Mandatory, Editorial Use Only, NO archive, NO Resale
Bild: © kabel eins Eigenproduktionsbild frei
Bild: © kabel eins
Bild: © kabel eins
Meistgelesene TV-News
- "Grey's Anatomy": An diesem Tag startet die 22. Staffel in Deutschland
- "Dutton Ranch": Dann startet das "Yellowstone"-Spin-off mit Kelly Reilly und Cole Hauser
- "Stranger Things"-Star übernimmt Hauptrolle in Netflix-Bestselleradaption
- Die "Totenfrau" kehrt zurück: Deutsche Free-TV-Premiere für Staffel 2
- "Kommissar Rex": Sat.1 holt auch Originalserie zurück
Neueste Meldungen
Quoten: "Die Maiwald" muss sich "Dänemark-Krimi" deutlich geschlagen geben
"Inside Transformers": ProSieben Maxx beleuchtet den Erfolg von Optimus Prime und Co.
"Julia Leischik sucht: Bitte melde dich": Neue Folgen in Sicht
Prime-Video-Highlights im April: Finale für "The Boys", "Pumuckl treibt Schabernack" und "Das Geisterhaus"
Die Vorschau - Unser neuer Podcast

Mario präsentiert die besten Serienstarts der kommenden Woche.
Newsletter
Abonniere unseren kostenlosen wöchentlichen Newsletter mit allen TV- und Streamingstarts der Woche.